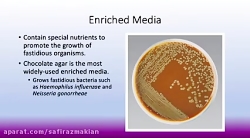
محیط کشت چیست و از کجا بخریم ؟

نتایج جستجو برای relaxing music channel growth YouTube (صفحه 2)
برچسب های مرتبط
موزیک آهنگ music
Music
موسیقی ترانه Music
persian music
کانال channel asal
iranian music
top persian music
Persian Pop Music
sorkhabi channel
pop music
Trap Music
New music
Bass Music
آهنگ های بلوچی بلوچستان...
iran music
Iranian Music 2018
top music
channel
Relaxation ریلکسیشن
relax

ویدبید
ویدبید